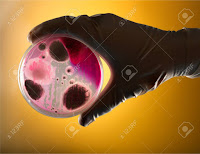

Fechas de clases - Fundamentos de biología
Lunes 25 de enero, 2021.
Jueves 28 de enero, 2021.
Viernes 29 de enero,2021.
Lunes 1 de enero,2021.
Jueves 4 de febrero,2021.
Lunes 8 de febrero,2021.
Jueves 11 de febrero,2021.
Lunes 15 de febrero,2021.
Lunes 1 de marzo,2021.
Jueves 11 de marzo,2021.
Lunes 26 de abril,2021.

Comentarios
Publicar un comentario